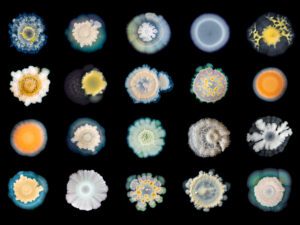

Now in its second year, Photo London is an ambitious programme of displays, talks, awards and events to provide a nexus between all the different elements of photography being created, disbursed, published, bought and sold in the UK today. At its heart lies a traditional art fair with works from 85 of the world’s leading galleries for sale in Somerset House’s labyrinthine rooms and a temporary courtyard pavilion.
But this is not your average trade fair and the layout feels very different from the exhibition halls and temporary structures of most art fairs today. Private galleries seem to have responded to the intimate spaces offered by Somerset House and curated displays and special collections that welcome browsing for those with a passing interest as well as serious collectors. For example, displays such as the contrived melodramas of Antonio Caballos’s Fotonovelas question the purpose of photography as a populist art form and Prabuddha Dasgupta’s beautiful series on women turns the objectification of the female form (seen in many other places of the fair) on its head by taking body parts almost to the level of abstraction.
Meanwhile Miron Zownir projects gritty insights into all the clichés of New York city in the early 1980s in a more removed manner to Larry Clark’s raw images of heroin addiction in Tulsa, and Yoshinori Mizutani’s specially commissioned London 2016 celebrates the natural diversity of London’s parks and streets in a manner that reflects the cherry-blossom-mania that engulfs his native Japan. All amongst glamourous, classic photography from Helmut Newton, Irving Penn and Cecil Beaton. Wandering through the fair the casual observer will make myriad connections between pieces and lose themselves in the maze of genres and possibilities to the extent that it can be a struggle to make sense of it all.
While commerce lies at the heart of Photo London it is far from its only element. A series of talks over the four days saw photographers from around the world, including Nick Knight, Mary McCartney, Don McCullin, Alec Soth, Martin Parr, Edward Burtynsky and Hannah Starkey in conversation with a host of creative practitioners such as David Campany, Edmund de Waal and Hans-Ulrich Obrist. Meanwhile, special exhibitions put the spotlight on artists in some of Somerset House’s dedicated exhibition spaces and across the site (as in Wolfgang Tillmans’ timely display of his EU ‘Remain’ campaign posters, Building Bridges, displayed in the public pavilion).
Curated by the Multimedia Art Museum, Moscow, Sergey Chilikov’s Photoprovocations in the West Embankment Galleries shows private lives behind the post-Soviet system of the 1990s. With minimal display texts and little context, Chilikov captures sometimes bizarre worlds (an exotic indoor garden for example), bored housewives and the forced poses of awkward teenagers in an attempt to understand the individuals of a political order that had placed such emphasis on the importance of group thinking. Craigie Horsfield’s Twelve in the East Embankment Galleries emphasises the collaborative process of photography and attempts to bring the viewer into this relationship, alongside his 1994 text published in ArtForum on his travels to Cracow and his encounters with a young Polish illustrator.
Meanwhile The Magic Lantern Show in Somerset House’s subterranean Deadhouse brings together London street photography by Matt Stuart and projections of work by Marina Sersale, Bredun Edwards and The Lurkers – with Edwards and Sersale being notable as two of the few photographers using their iphones to capture the immediacy of a London that is disappearing so rapidly, a London of council tower blocks and municipal playgrounds.
Although many practitioners today use digital photography in some form, the majority of Photo London is a celebration of the physical object or of the nuances of printing processes. From archival pigment prints, gelatin silver prints and c-prints to hand-finished inkjet prints, the works highlight that photography doesn’t stop at the subject and the composition. A preview of artistic duo Walter & Zoniel’s new series, The Untouched, reviving a nineteenth-century technique known as tintype, reflects this with life-size portraits of British icons displayed in the Stamp Staircase alongside a video of the artists’ process.
In a time when everyone’s a photographer (Photo London helpfully reveals that 400 million people now share over 80 million images online daily), it is becoming more and more difficult for artists to be noticed and stand out amongst the rest. As with any art fair, the sheer volume of works on display at Photo London quickly becomes overwhelming but the value of the event lies, for non-collectors at least, in its pockets of sanity which emphasise the importance of curation. The exhibition shows the value of putting pieces together well as much as the value of the individual pieces. Whether it’s gritty realism, otherworldly double exposures or high octane celebrity glamour that you are after, it’s all covered by Photo London, capturing a significant, if overwhelming, insight into the state of photography today.
Ruby Beesley
Photo London ran from 19-22 May at Somerset House.
Credits:
1. Carmen Mitrotta, Call to Faith no.2 (2013). Courtesy of Bidhalle, Zurich.